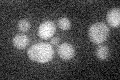
YDL084W
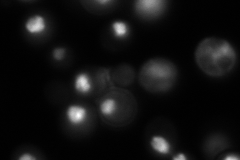
YDL084W
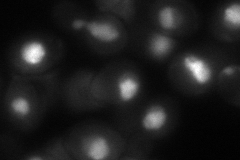
YDL084W

View description
Component of the TREX complex required for nuclear mRNA export; member of the DEAD-box RNA helicase superfamily and is involved in early and late steps of spliceosome assembly; homolog of the human splicing factor hUAP56
Localization:
Intensity:
Fold change:
Significance:
-
C’ GFP library in SD
below threshold17.19 -
N' NOP1pr-GFP in SD

nucleus388.127 -
N' TEF2pr-mCherry in SD

nucleus423.311 -
N' NATIVEpr-GFP in SD
nucleus225.324 -
N' TEF2pr-VC and Cyto-VN in SD
punctate,nucleus88.6608 -
C’ GFP library in SD+DTT

cytosol14.580.84No -
C’ GFP library in SD+H2O2

cytosol17.571.02No -
C’ GFP library in Starvation Media

cytosol18.591.08No -
C’ GFP library on the background of Pup2-DaMP

below threshold -
C’ GFP library on the background of CCT mutant

below threshold17.36291.00966No
